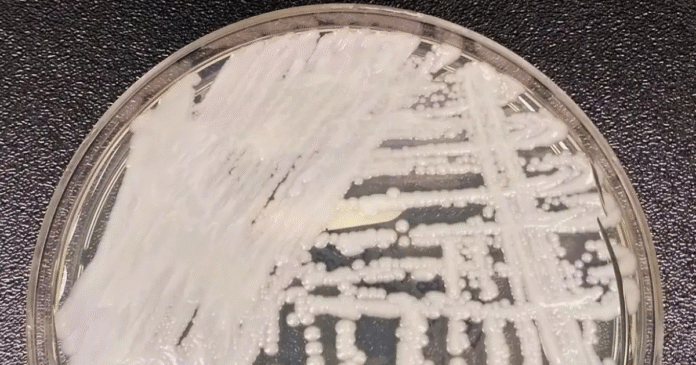

Centro de Prevenção de Doenças pede medidas para conter disseminação
Por Lusa – Publicado em 11/09/2025 – 14:11
O Centro Europeu de Prevenção e Controle das Doenças (ECDC) alertou nesta quinta-feira (11) para a rápida propagação nos hospitais do fungo Candidozyma auris (C.auris), resistente a medicamentos, e pediu que sejam tomadas medidas para travar sua disseminação.

Em comunicado, o ECDC indica que de 2013 a 2023 foram registrados mais de 4 mil casos nos países da UE/EEE (inclui a Islândia, o Liechtenstein e a Noruega), destacando “um salto significativo” em 2023, ano em que foram divulgados 1.346 casos em 18 países.
A instituição destaca assim “a importância da detecção precoce e do controle da transmissão para evitar a disseminação rápida e generalizada” do C. auris, anteriormente Candida auris.
De acordo com o levantamento de 2024 da agência da União Europeia (UE) para identificar as ameaças para a saúde devido a doenças, “o número de casos está aumentando, os surtos estão crescendo e vários países enfrentam uma transmissão local contínua”.
O último estudo do centro sobre o fungo mostra também “lacunas na vigilância e na preparação para o controle de infeções”.
Propagando-se geralmente em instalações de saúde, o C. auris é “frequentemente resistente a medicamentos antifúngicos e pode causar infecções graves em doentes críticos”, sendo o seu controle bastante difícil devido à “capacidade de persistir em diferentes superfícies e equipamentos médicos e de se espalhar entre doentes”.
Representa assim “séria ameaça para os doentes e para os sistemas de saúde”, diz o ECDC.
“O C. auris espalhou-se em apenas alguns anos – desde casos isolados até se generalizar em alguns países. Isto mostra a rapidez com que pode se estabelecer nos hospitais”, afirmou Diamantis Plachouras, chefe da equipe de Resistência Antimicrobiana e Infeções associadas aos cuidados de saúde do ECDC, citado no comunicado.
“Mas isso não é inevitável”, acrescentou, assinalando que “a detecção precoce e o controle rápido e coordenado da infecção podem prevenir novas transmissões”.
Espanha, Grécia, Itália, Romênia e Alemanha foram os países com a maioria dos casos ao longo da década, tendo sido registrados “surtos recentes no Chipre, na França e Alemanha, enquanto a Grécia, Itália, Romênia e Espanha indicaram que já não conseguem distinguir surtos específicos devido à ampla disseminação regional ou nacional”.
“Em vários desses países, a transmissão local sustentada ocorreu apenas alguns anos após o primeiro caso documentado”, segundo o ECDC, que considera existir um “período decisivo para intervenções precoces de forma a travar a propagação” do fungo.
O organismo europeu diz que alguns países demonstraram “resultados positivos na limitação de surtos de C. auris”, chamando a atenção para a existência de “lacunas importantes” em muitos outros.
“Apesar do aumento do número de casos, apenas 17 dos 36 países participantes têm atualmente um sistema nacional de vigilância para o C. auris” e “somente15 desenvolveram orientações nacionais específicas para a prevenção e controle de infecções”.
Alerta ainda que o fato de não existir “vigilância sistemática e notificação obrigatória” significa que podem existir mais casos não divulgados.
No período entre 2013 e 2023, Portugal registrou apenas quatro casos de C. auris em 2023, enquanto a Espanha e a Grécia anunciaram 1.807 e 852, respectivamente.